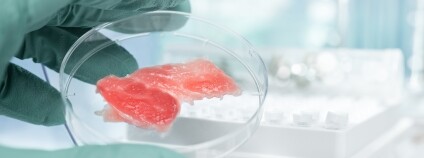
Foto: anyaivanova@gmail.com / Depositphotos

reklama
reklama
PřírodaPortál MiSe Klima - nový digitální průvodce klimatickou změnou28.4.2024 | PRAHA
(Ekolist.cz)
 Nový digitální průvodce nabízí široké veřejnosti veškeré informace o klimatických opatřeních, která pomáhají zmírňovat dopady změny klimatu. Základ portálu tvoří jejich katalog, který byl sestaven pracovníky poradenských center financovaných v rámci projektu LIFE COALA. K dispozici jsou publikace, metodiky a knihy, kde lze získat bližší představu, jak opatření fungují. Nový digitální průvodce nabízí široké veřejnosti veškeré informace o klimatických opatřeních, která pomáhají zmírňovat dopady změny klimatu. Základ portálu tvoří jejich katalog, který byl sestaven pracovníky poradenských center financovaných v rámci projektu LIFE COALA. K dispozici jsou publikace, metodiky a knihy, kde lze získat bližší představu, jak opatření fungují.
Vychuchol pyrenejský připomíná krtka i ptakopyska. Španělští experti se ho snaží zachránit před vymřením27.4.2024 | MADRID
(ČTK)
 Španělská vláda i Mezinárodní svaz ochrany přírody zintenzivnily snahy o záchranu nepříliš známého živočicha, který vypadá trochu jako krtek, trochu jako potkan a trochu jako ptakopysk a žije už jen v několika málo oblastech severu Španělska a Portugalska či jihu Francie. Jmenuje se vychuchol pyrenejský a k životu potřebuje čisté bystřiny. Právě proto mu možná už do deseti let hrozí vymření, informoval tento týden deník El País. Španělská vláda i Mezinárodní svaz ochrany přírody zintenzivnily snahy o záchranu nepříliš známého živočicha, který vypadá trochu jako krtek, trochu jako potkan a trochu jako ptakopysk a žije už jen v několika málo oblastech severu Španělska a Portugalska či jihu Francie. Jmenuje se vychuchol pyrenejský a k životu potřebuje čisté bystřiny. Právě proto mu možná už do deseti let hrozí vymření, informoval tento týden deník El País.Drony vyvinuté na ČVUT pomáhají s mapováním znečištěných vodních ploch27.4.2024
(ČTK)
 Drony vyvinuté na Českém vysokém učení technickém (ČVUT) pomáhají s přesnějším a rychlejším mapováním znečištěných vodních ploch, hledáním sinic a odpadků. Dokážou to ve spolupráci s autonomně řízenými loděmi. Skupina multirobotických systémů (MRS) Fakulty elektrotechnické ČVUT představila v pondělí své výsledky u břehů vodní nádrže Orlík. Drony vyvinuté na Českém vysokém učení technickém (ČVUT) pomáhají s přesnějším a rychlejším mapováním znečištěných vodních ploch, hledáním sinic a odpadků. Dokážou to ve spolupráci s autonomně řízenými loděmi. Skupina multirobotických systémů (MRS) Fakulty elektrotechnické ČVUT představila v pondělí své výsledky u břehů vodní nádrže Orlík.Dotační hřebík do rakve přírodě šetrnému zemědělství27.4.2024 | PRAHA
(Ekolist.cz)
 Evropský parlament 24. dubna podpořil návrh Evropské komise radikálně oslabit ekologické podmínky pro čerpání veřejných peněz ze zemědělských dotací v rámci Společné zemědělské politiky. O tom, co to znamená, informují ve společné tiskové zprávě Hnutí DUHA, Česká společnost ornitologická a WWF v Česku. Evropský parlament 24. dubna podpořil návrh Evropské komise radikálně oslabit ekologické podmínky pro čerpání veřejných peněz ze zemědělských dotací v rámci Společné zemědělské politiky. O tom, co to znamená, informují ve společné tiskové zprávě Hnutí DUHA, Česká společnost ornitologická a WWF v Česku.
Svahy Lovoše v Českém středohoří pokryly opuncie, kaktusy původem z Ameriky26.4.2024 | LOVOSICE
(ČTK)
 Svahy kopce Lovoš v Českém středohoří pokryly opuncie, kaktusy původem z Ameriky. Botanici z přítomnosti rostliny v unikátní stepi velkou radost nemají, chová se invazně, bere prostor chráněným druhům, proto proti ní zasahují. ČTK to řekla botanička z Chráněné krajinné oblasti České středohoří Kateřina Tremlová. Svahy kopce Lovoš v Českém středohoří pokryly opuncie, kaktusy původem z Ameriky. Botanici z přítomnosti rostliny v unikátní stepi velkou radost nemají, chová se invazně, bere prostor chráněným druhům, proto proti ní zasahují. ČTK to řekla botanička z Chráněné krajinné oblasti České středohoří Kateřina Tremlová.Průzkum: Za polovinu světového znečištění plasty je zodpovědných 56 firem26.4.2024
(ČTK)
 Za více než polovinu světového znečištění plasty je zodpovědných 56 firem. Z toho šest jich ke znečištění planety přispívá z jedné čtvrtiny a s odstupem největší podíl má na tom společnost Coca-Cola. Zjistil to průzkum, jehož výsledky na svém webu zveřejnil britský deník The Guardian. Za více než polovinu světového znečištění plasty je zodpovědných 56 firem. Z toho šest jich ke znečištění planety přispívá z jedné čtvrtiny a s odstupem největší podíl má na tom společnost Coca-Cola. Zjistil to průzkum, jehož výsledky na svém webu zveřejnil britský deník The Guardian.Krkonošské louky mohou dál rozkvétat26.4.2024 | PRAHA
(Ekolist.cz)
 Krkonošské louky nezůstanou ladem. Správa KRNAP letos navazuje v péči o krkonošské louky již třetím projektem Management sekundárního bezlesí Krkonošského národního parku. Právě začínající projekt potrvá až do roku 2029 a obnovíme díky němu druhově bohaté luční porosty na výjimečných krkonošských loukách v celém druhotném (tedy lidskou prací vzniklém a udržovaném) bezlesí Krkonošského národního parku. Značná část krkonošských luk v minulosti degradovala kvůli zániku tradičního citlivého hospodaření trvajícího více než 400 let (v důsledku vysídlení původního německého obyvatelstva po roce 1945), nebo naopak přílišnou intenzifikací hospodaření v posledních desetiletích 20. století. Krkonošské louky nezůstanou ladem. Správa KRNAP letos navazuje v péči o krkonošské louky již třetím projektem Management sekundárního bezlesí Krkonošského národního parku. Právě začínající projekt potrvá až do roku 2029 a obnovíme díky němu druhově bohaté luční porosty na výjimečných krkonošských loukách v celém druhotném (tedy lidskou prací vzniklém a udržovaném) bezlesí Krkonošského národního parku. Značná část krkonošských luk v minulosti degradovala kvůli zániku tradičního citlivého hospodaření trvajícího více než 400 let (v důsledku vysídlení původního německého obyvatelstva po roce 1945), nebo naopak přílišnou intenzifikací hospodaření v posledních desetiletích 20. století.
Na vybraných místech Prahy budou letos opět spásat trávu ovce, kozy a krávy25.4.2024 | PRAHA
(ČTK)
 Na vybraných místech Prahy budou letos opět spásat trávu ovce, kozy a krávy. V chráněných lokalitách budou konkrétně dvě stáda krav a čtyři stáda ovcí a koz. Pražané mohou nyní zvířata vidět třeba v Podbabských skalách, v Prokopském nebo Bohnickém údolí. Město se k tradičnímu způsobu údržby vybraných pozemků vrátilo v roce 2000. Zvířata si půjčuje od soukromých zemědělců, uvedl mluvčí města Vít Hofman. Na vybraných místech Prahy budou letos opět spásat trávu ovce, kozy a krávy. V chráněných lokalitách budou konkrétně dvě stáda krav a čtyři stáda ovcí a koz. Pražané mohou nyní zvířata vidět třeba v Podbabských skalách, v Prokopském nebo Bohnickém údolí. Město se k tradičnímu způsobu údržby vybraných pozemků vrátilo v roce 2000. Zvířata si půjčuje od soukromých zemědělců, uvedl mluvčí města Vít Hofman.Dřevinou s nejlepším zdravotním stavem v ČR je buk lesní, strádá borovice lesní25.4.2024 | PRAHA
(ČTK)
 Zdravotní stav lesů se loni ve srovnání s rokem 2022 mírně zlepšil, objem vytěženého kůrovcového dříví 3,2 milionu metrů krychlových ve smrkových porostech byl zhruba o třetinu menší než o rok dříve. Proti předchozím rokům jde sice o zlepšení, konec kůrovcové kalamity to ale neznamená. Dřevinou s nejlepším zdravotním stavem je v ČR nyní buk lesní, ke zhoršování stavu dochází u borovice lesní, řekli zástupci Výzkumného ústavu lesního hospodářství a myslivosti (VÚLHM). Zdravotní stav lesů se loni ve srovnání s rokem 2022 mírně zlepšil, objem vytěženého kůrovcového dříví 3,2 milionu metrů krychlových ve smrkových porostech byl zhruba o třetinu menší než o rok dříve. Proti předchozím rokům jde sice o zlepšení, konec kůrovcové kalamity to ale neznamená. Dřevinou s nejlepším zdravotním stavem je v ČR nyní buk lesní, ke zhoršování stavu dochází u borovice lesní, řekli zástupci Výzkumného ústavu lesního hospodářství a myslivosti (VÚLHM).V Brdech roubují ovocné stromy odrůdami ze zaniklých obcí24.4.2024
(ČTK)
Vojenské lesy a statky (VLS) naroubovaly na Padrťských pláních v Brdech téměř 300 ovocných stromů štěpy ze zaniklých obcí Padrť, Kolvín a Zaběhlá. Vesnice byly vystěhovány při rozšiřování vojenského prostoru v letech 1952 a 1953. Dnes je tam veřejně přístupná Chráněná krajinná oblasti Brdy. V nových alejích u cest tak budou stromy plodit odrůdy ovoce, které pěstovali obyvatelé zaniklých obcí, řekl ČTK ředitel divize VLS Hořovice David Novotný. Roubování zajistily VLS s dobrovolníky, stejně jako loni, kdy šlo o první stovku. Zájem o 'Brdské stromsázení' byl letos vyšší. Vojenské lesy a statky (VLS) naroubovaly na Padrťských pláních v Brdech téměř 300 ovocných stromů štěpy ze zaniklých obcí Padrť, Kolvín a Zaběhlá. Vesnice byly vystěhovány při rozšiřování vojenského prostoru v letech 1952 a 1953. Dnes je tam veřejně přístupná Chráněná krajinná oblasti Brdy. V nových alejích u cest tak budou stromy plodit odrůdy ovoce, které pěstovali obyvatelé zaniklých obcí, řekl ČTK ředitel divize VLS Hořovice David Novotný. Roubování zajistily VLS s dobrovolníky, stejně jako loni, kdy šlo o první stovku. Zájem o 'Brdské stromsázení' byl letos vyšší. |
reklama |
Ekolist.cz je vydáván občanským sdružením BEZK. ISSN 1802-9019. Za webhosting a publikační systém TOOLKIT děkujeme Ecn studiu. Navštivte Ecomonitor.
Copyright © BEZK. Copyright © ČTK, TASR. Všechna práva vyhrazena. Publikování nebo šíření obsahu je bez předchozího souhlasu držitele autorských práv zakázáno.
Copyright © BEZK. Copyright © ČTK, TASR. Všechna práva vyhrazena. Publikování nebo šíření obsahu je bez předchozího souhlasu držitele autorských práv zakázáno.

